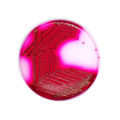
E-shop hlavní obrázek

Čokoládový agar s bacitracinem je selektivní půda určena k izolaci Haemophilus spp. z klinických vzorků se smíšenou flórou, zejména z respiračního traktu.

Čokoládový agar s bacitracinem je selektivní půda určena k izolaci Haemophilus spp. z klinických vzorků se smíšenou flórou, zejména z respiračního traktu.

Deoxycholát citrát agar je selektivní médium pro rody Salmonella, Shigella z klinických i neklinických vzorků.
Endo agar je selektivní a diagnostická půda, která se používá pro izolaci, kultivaci a diferenciaci Gram-negativních mikroorganismů, zejména Enterobacteriacae.

Gardova půda se používá k získání 24 hodinové kultury salmonel pro sklíčkovou aglutinaci.

Haemophilus test medium je standardizované pevné médium doporučené pro testování antimikrobiální citlivosti Haemophilus influenzae.

Chromagar orientation slouží k identifikaci Enterobacteriaceae hlavně z močového traktu. Bakterie na základě různých chromogenních substrátů, rostou v typicky zbarvených koloniích.

Krevní agar s NaCl se používá jako selektivní medium pro stafylokoky.

Agarové médium Columbia s ovčí krví doplněné inhibiční směsí (kolistin + kyselina oxolinová + amphotericin) je selektivní médium pro streptokoky. Používá se rovněž k průkazu hemolytických reakcí. Médium se používá pro analýzu směsných vzorků bakteriální flóry, například vzorků z genitálního traktu.

Selektivní médium k průkazu a kultivaci různých druhů rodu Legionella z enviromentálních a klinických vzorků.

MacConkey agar je selektivní a diagnostická půda, která se používá pro izolaci, kultivaci a diferenciaci Gram-negativních mikroorganismů, zejména Enterobacteriacae.

MacConkey agar se sorbitolem se používá pro izolaci enteropatogenního E. coli O157:H7.

MAL agar rozšířuje a zlepšuje podmínky pro izolaci a diferenciaci patogenních střevních mikroorganismů, které poskytuje XLD agar. Je určený k záchytu sirovodík pozitivních salmonell (jiných než S.typhi) a na rozlišení mannitolpozitivních a mannitolnegativních enterobakterií.

Mannitol Salt Agar je selektivní médium pro izolaci a stanovení počtu stafylokoků. Používá se rovněž k diferenciaci manitol fermentujících a manitol nefermentujících druhů.

MH agar obohacený 5% defibrinované koňské krve a 20 mg/l ß-NAD se používá pro testování ATB citlivosti diskovou difúzní metodou Streptococcus spp., S.pneumoniae, Haemophilus spp., M.catarrhalis, Campylobacter spp. a dalších náročných bakterií.

Mycosel agar je vysoce selektivní medium určené izolaci dermatofytů a dalších patogenních mikromycet ze vzorků masivně kontaminovaných průvodní mikroflórou.

Neisseria gonorrhoeae agar je obohacená kultivační půda, která se používá jako médium k primokultivaci nebo subkultivaci ze vzorků obsahujících smíšenou flóru bakterií a plísní.

Neisseria gonorrhoeae selektivní agar je obohacená kultivační půda, která se používá pro selektivní izolaci patogenních Neisseria ze vzorků obsahujících smíšenou flóru bakterií a plísní.